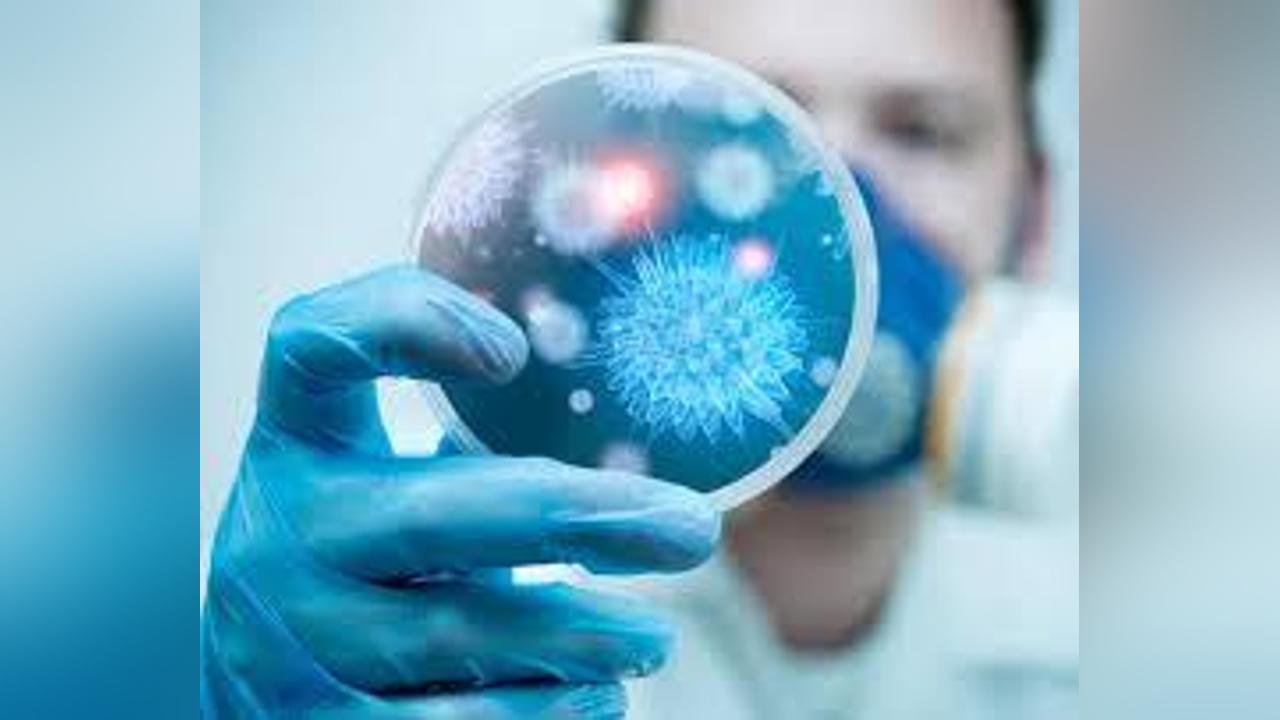

Africa-Press – Djibouti. Les épidémies de grippe tuent chaque année un demi-million de personnes dans le monde, et entre 10.000 et 15.000 personnes en France. Ces virus peuvent également faire des ravages chez les animaux, comme dans le cas de la grippe aviaire, qui a touché 81 élevages français en mai 2023. Une équipe de l’Université de Genève (UNIGE) a identifié le mécanisme d’intrusion dans les cellules du virus de la grippe A. Les résultats sont publiés dans la revue PNAS.
Grippes A et B
Contrairement au virus influenza B, dont le réservoir est strictement humain, le virus influenza A se trouve à l’origine chez certaines espèces d’oiseaux aquatiques migrateurs, en particulier les canards ou les oies. Il entraine une maladie anthropozoonotique, c’est-à-dire une maladie qui peut franchir la barrière des espèces, et se transmettre chez les mammifères, dont les humains. C’est la grippe ! Les différences au niveau des symptômes sont minimes, et les deux virus provoquent des risques de pneumonie.
« J’ai été assez surpris de constater qu’une seule protéine pouvait avoir un effet aussi important sur un virus »
Les scientifiques ont d’abord identifié la protéine utilisée par le virus pour entrer dans la cellule : le récepteur de la transferrine 1. Les chercheurs ont ensuite « utilisé des ciseaux génétiques, appelés CRISPR/Cas9, pour générer des cellules pulmonaires dépourvues de récepteur de la transferrine 1. Celles-ci étaient peu infectables par les virus de la grippe A », explique Mirco Schmolke, professeur associé à l’Université de Genève et coauteur de cette étude.
La suppression du gène de ce récepteur a réduit de 50 à 60 % la réplication précoce du virus de la grippe. « Cela nous a montré que le récepteur de la transferrine était non seulement nécessaire mais aussi suffisant pour pénétrer dans les cellules hôtes. J’ai été assez surpris de constater qu’une seule protéine pouvait avoir un effet aussi important sur un virus », poursuit le microbiologiste. En se fixant sur ce récepteur à la surface de la cellule, le virus détourne le mécanisme de transport du fer pour démarrer son cycle infectieux.
Pour adapter cette technique à l’Homme, les chercheurs devront néanmoins trouver un inhibiteur chimique adapté, car celui utilisé lors des phases de tests est considéré comme toxique.
Une stratégie prometteuse pour traiter l’Homme et potentiellement l’animal
En se servant directement d’une protéine de l’hôte, les chercheurs répondent à un problème très fréquent dans le développement de médicaments antiviraux : les mutations du virus, à l’origine de variantes résistantes au médicament contre la souche initiale. « Nous espérons que les spécialistes dans le domaine du développement de médicaments antiviraux pourront reprendre nos résultats et les traduire en un médicament pour l’Homme », affirme Mirco Schmolke, sur la perspective de ses résultats.
Les infections par le virus de la grippe A peuvent également être très mortelles pour les animaux domestiques, en particulier les volailles (grippe aviaire). « Malheureusement, le traitement des animaux sera probablement trop coûteux sur le marché concurrentiel de la production de viande. Classiquement, les épidémies chez les volailles sont résolues par l’abattage », déplore le chercheur. C’est près de 900.000 volailles qui ont été abattues en mai 2023 dans les élevages français. Une première campagne de vaccination des animaux d’élevage contre la grippe aviaire a été annoncée à l’automne 2023 par le ministère de l’Agriculture.
Pour plus d’informations et d’analyses sur la Djibouti, suivez Africa-Press